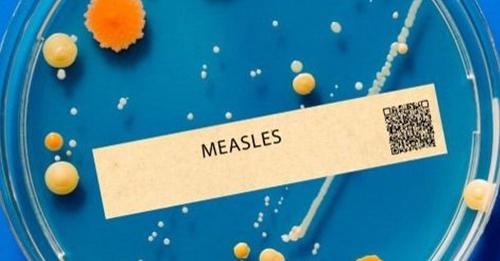

Nem mindennapi módszereket javasolt a
Nem mindennapi módszereket javasolt a szakember

Nincs békefolyamat Oroszország nélkül – jelentette ki kedden Ignazio Cassis svájci…


Ukrajna az amerikai lassúság miatt már elvesztette a…




Az új jogszabály szerint akár 2 év börtönt is kaphatnak…